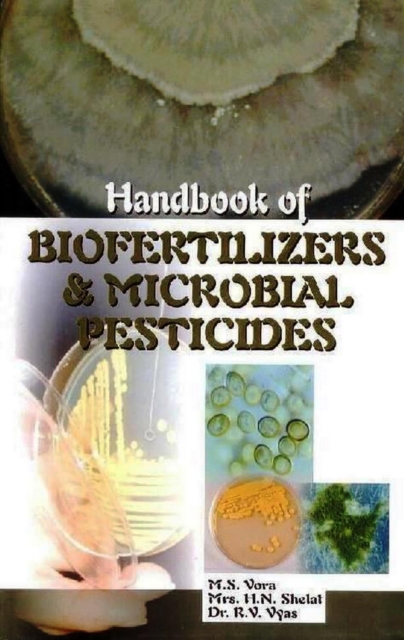

Handbook of Biofertilizers and Microbial Pesticides
Available
An effort has been made to provide knowledge of biofertilizers and microbial pesticides with microbiological techniques required for maintenance and use. Chemical fertilizers and pesticides have provided foot for first green revolution which is now switches to use of biofertilizers and microbial pesticides in current era of organic farming and ecofriendly management practices for which all informa...
Read more
E-book
epub
Price
299.99 £
An effort has been made to provide knowledge of biofertilizers and microbial pesticides with microbiological techniques required for maintenance and use. Chemical fertilizers and pesticides have provided foot for first green revolution which is now switches to use of biofertilizers and microbial pesticides in current era of organic farming and ecofriendly management practices for which all informa...
Read more
Follow the Author
